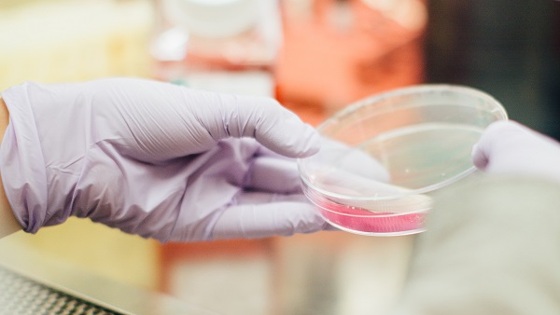

Онколог рассказал о мутации раковых клеток
Главный внештатный онколог Министерства здравоохранения России, гендиректор ФГБУ "НМИЦ радиологии", президент Ассоциации онкологов России
рассказал о том, что раковые клетки могут приспосабливаться к лечению, а также переставать реагировать на терапию, передает РИА Новости. По словам Карпина, медики до сих пор не могут до конца разобраться с этой болезнью из-за ее постоянных мутаций. Так, он рассказал, что бывают такие случаи, когда пациента лечат сложнейшими препаратами, но потом возникает резистентность и лекарства перестают действовать на опухоль. Иногда даже, по его словам, врачам приходилось возвращаться к первому варианту химиотерапии. Дело в том, что последующие теряли свою эффективность.
Ранее
врач назвал главную ошибку людей с больной спиной
.